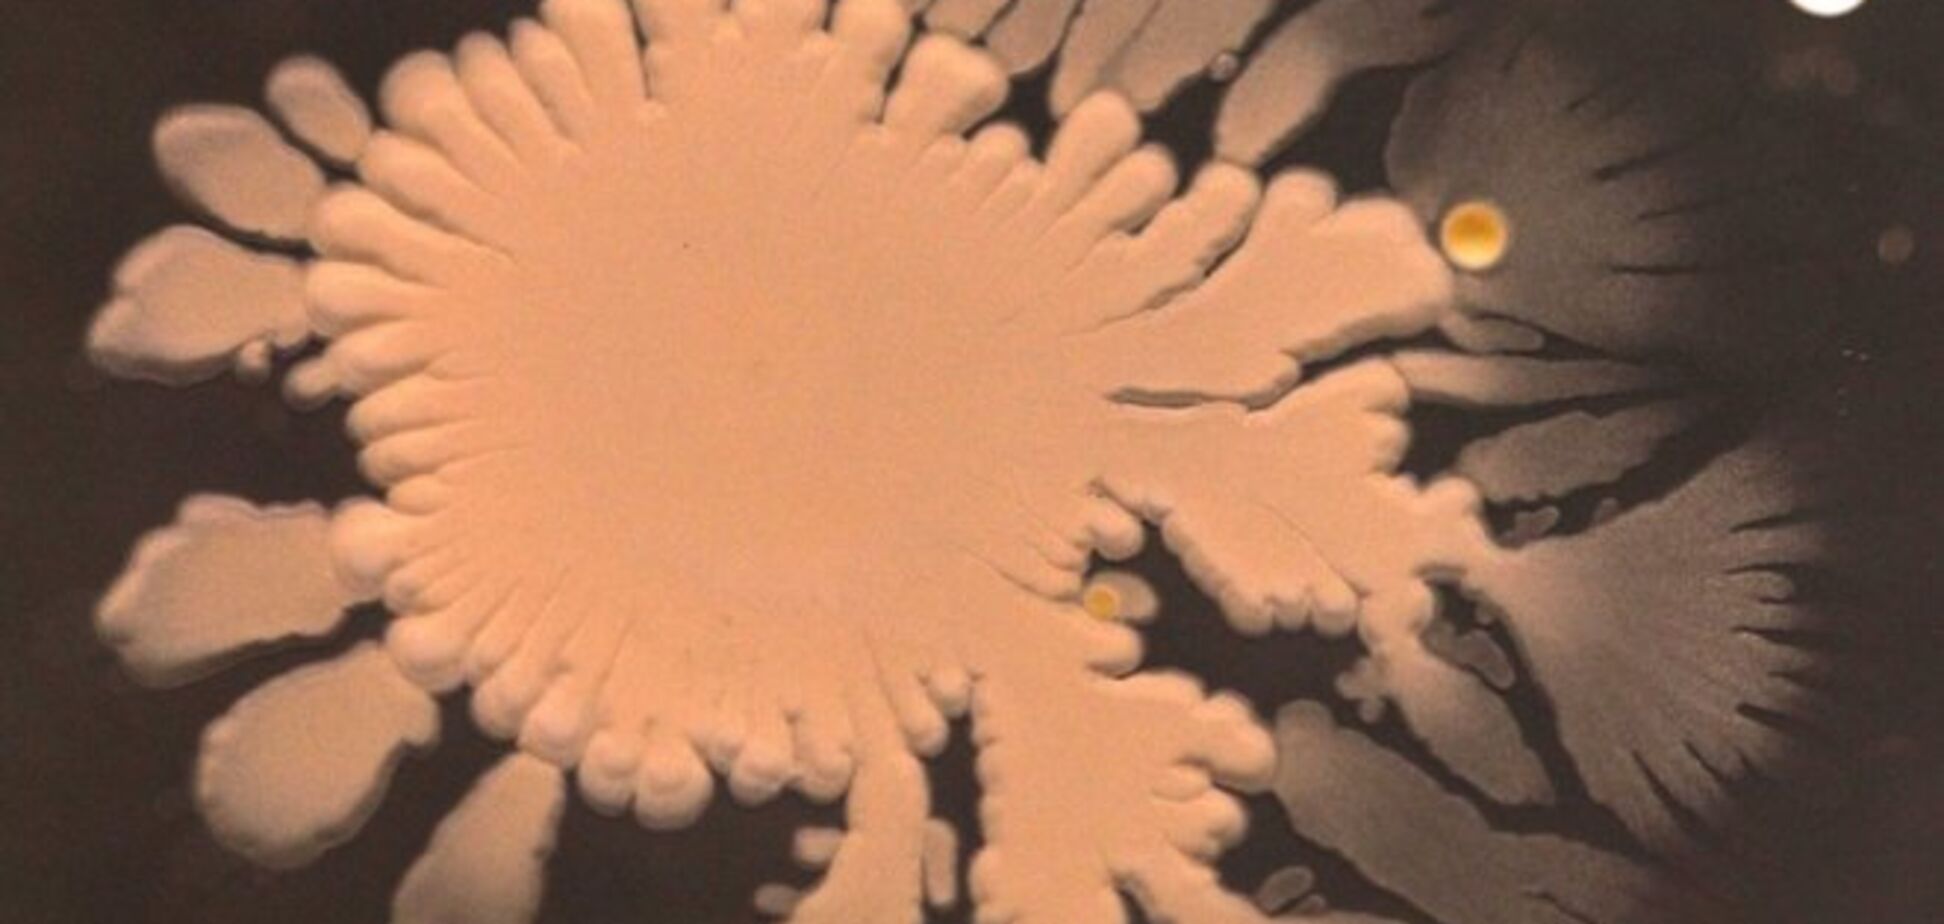
Ученые начали искать пришельцев глубоко под землей

Ученые начали искать пришельцев глубоко под землей
Ученые из Йельского университета заявили, что инопланетяне живут в буквальном смысле у нас под ногами. Исследователи уверены, что пришельцы обитают на глубине 19 километров под землей в условиях экстремальных температур и высокого давления.
О том, что инопланетные организмы могут существовать глубоко под землей, исследователи всерьез задумались после того, как обнаружили особые изотопы углерода в древних породах арагонита на побережье американского острова Лопез (штат Вашингтон, США). Есть версия, что минералы образовались под воздействием жидкости, богатой метаном органического происхождения, пишет сообщает Business Insider.
По мнению исследователей, подземная среда достаточно благоприятна для существования внеземной жизни, поскольку защищает организмы от губительной космической радиации и высоких температур на поверхности.
Читайте: Ученые нашли черную дыру, которая вызвала "бурю" в галактике
Ранее "Обозреватель" сообщал, что NASA будет искать внеземную жизнь в Солнечной системе.










